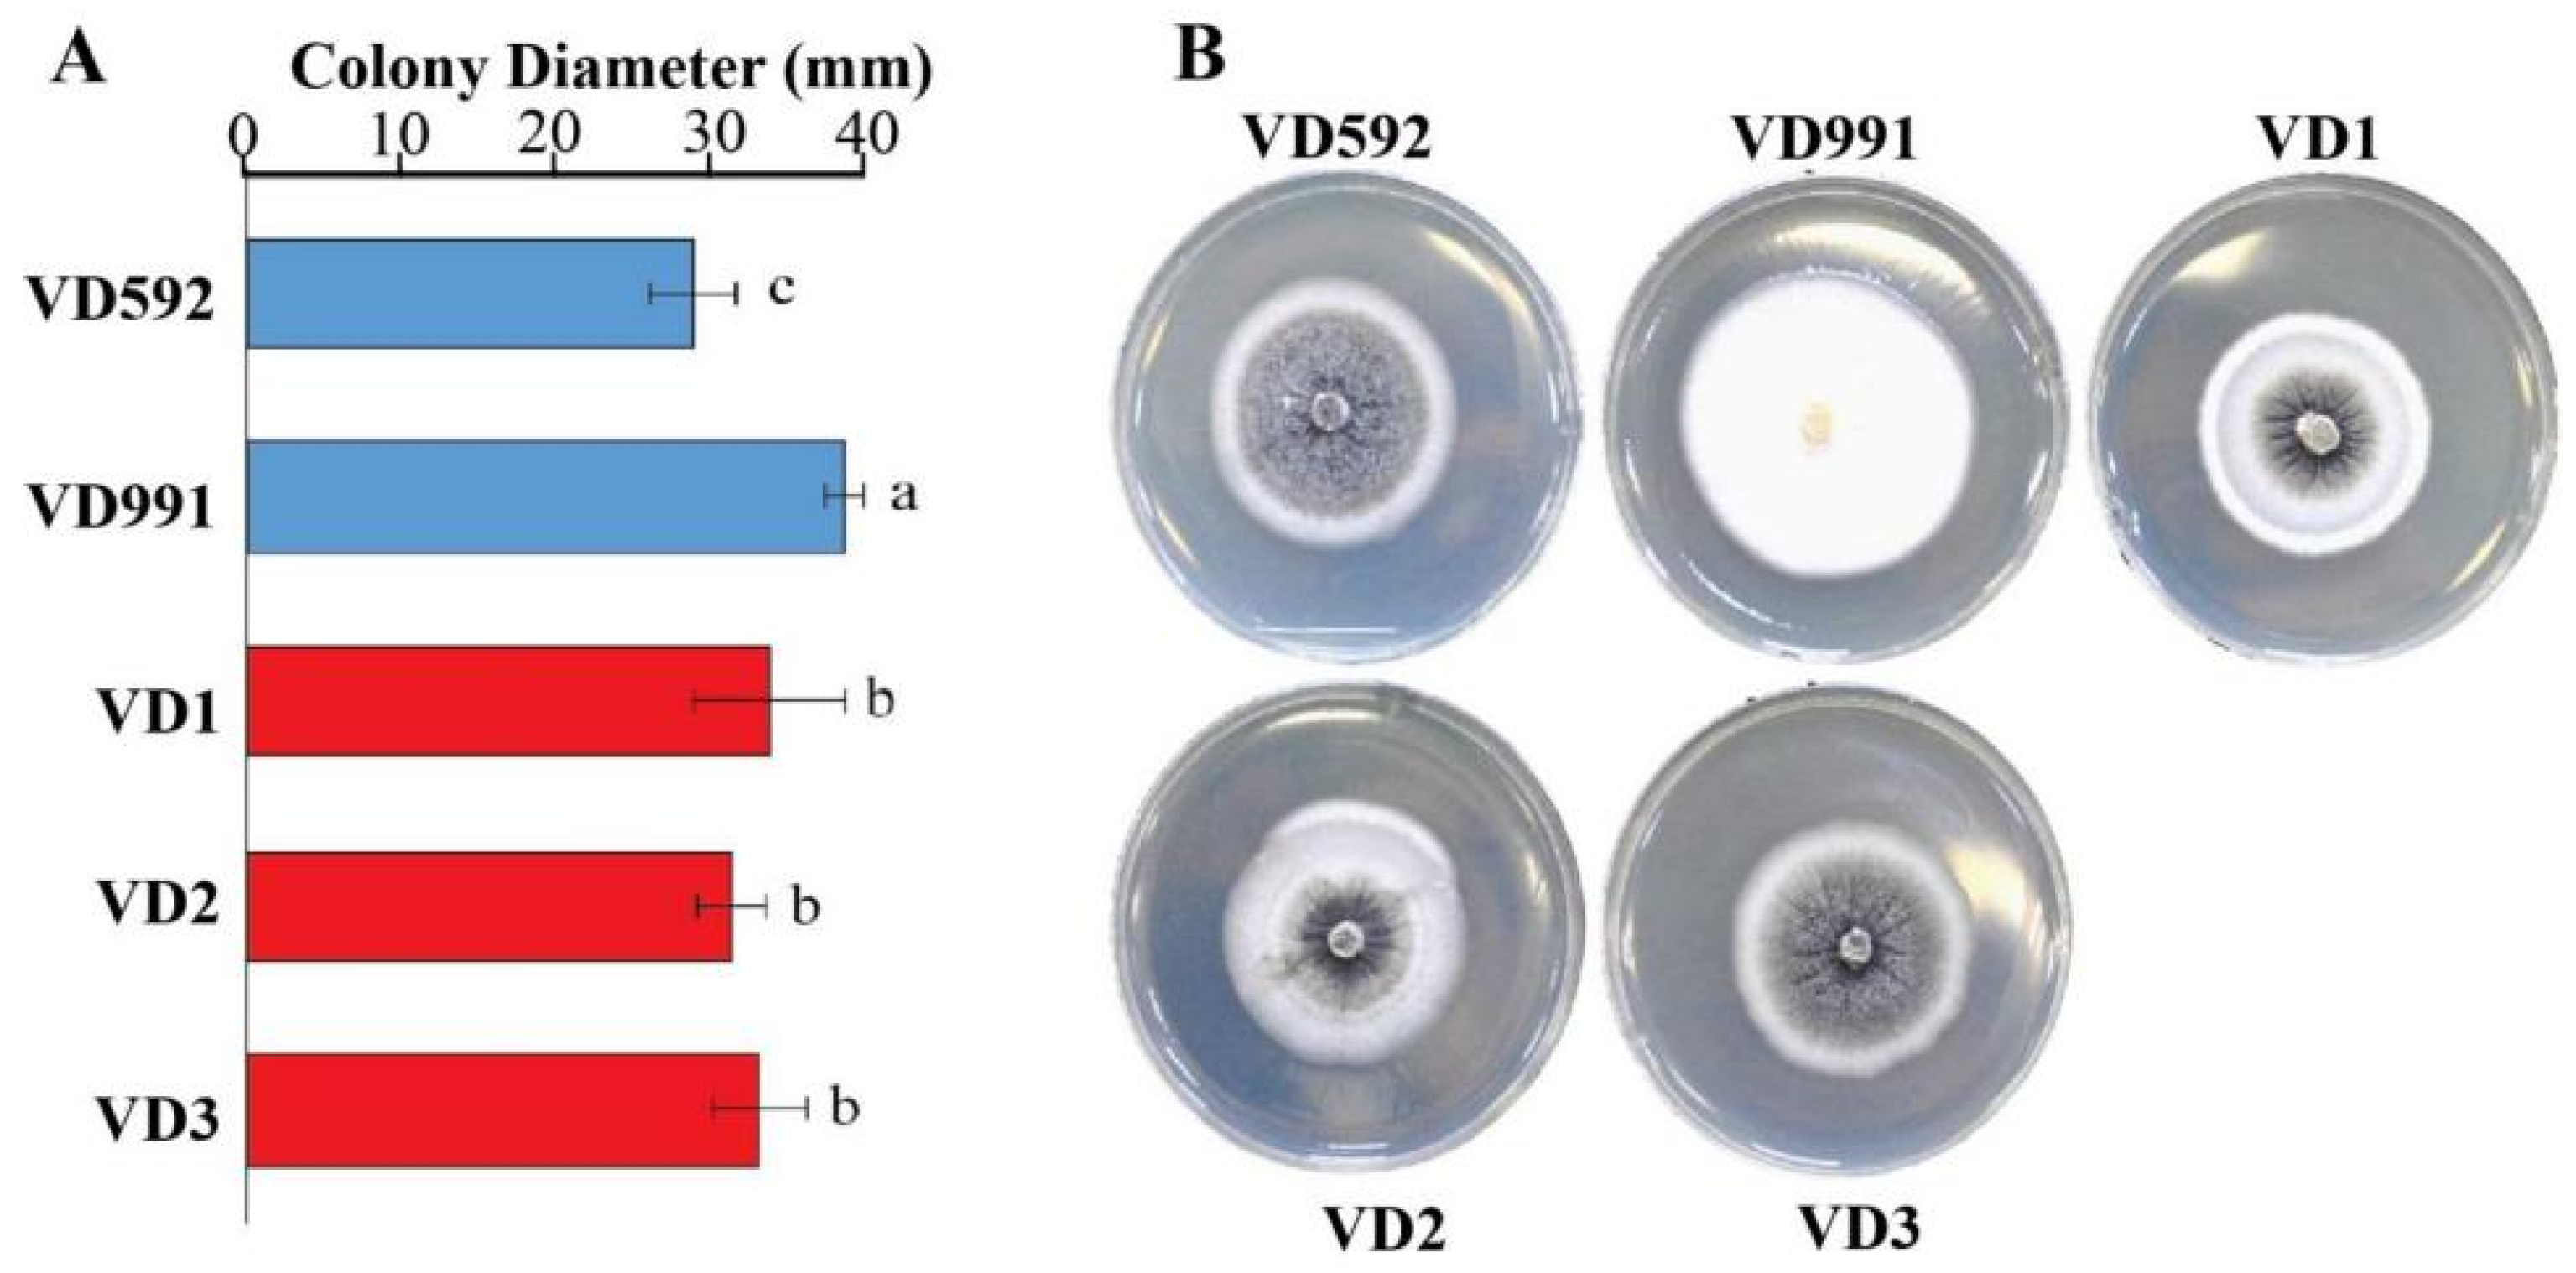

Distribution and Pathogenicity Differentiation of Physiological Races of Verticillium dahliae from Cotton Stems in Western China
Abstract
1. Introduction
2. Materials and Method
2.1. Plant Materials and V. dahliae Strains
2.2. Isolation, Identification, and Characterization of V. dahliae Isolates
2.3. Genetic Diversity of Verticillium Isolates
2.4. Pathogenicity Assays for Isolates
3. Data Analysis
4. Results
4.1. Isolation of V. dahliae
4.2. Phylogenetic Analyses of ACT, EF, GPD, and TS Regions
4.3. Genetic Diversity and Pathotypes
4.4. Worldwide Haplotypes Analysis of V. dahliae
4.5. Pathogenicity Determination of Fungal Isolates
5. Discussion
6. Conclusions
Supplementary Materials
Author Contributions
Funding
Institutional Review Board Statement
Informed Consent Statement
Data Availability Statement
Acknowledgments
Conflicts of Interest
References
- Inderbitzin, P.; Davis, R.; Bostock, R.; Subbarao, K. Identification and Differentiation of Verticillium Species and V. longisporum Lineages by Simplex and Multiplex PCR Assays. PLoS ONE 2013, 8, e65990. [Google Scholar] [CrossRef] [PubMed]
- Atallah, Z.K.; Maruthachalam, K.; du Toit, L.; Koike, S.T.; Davis, R.M.; Klosterman, S.J.; Hayes, R.J.; Subbarao, K.V. Population Analyses of the Vascular Plant Pathogen Verticillium dahliae Detect Recombination and Transcontinental Gene Flow. Fungal Genet. Biol. 2010, 47, 416–422. [Google Scholar] [CrossRef] [PubMed]
- Song, R.; Li, J.; Xie, C.; Jian, W.; Yang, X. An Overview of the Molecular Genetics of Plant Resistance to the Verticillium Wilt Pathogen Verticillium dahliae. Int. J. Mol. Sci. 2020, 21, 1120. [Google Scholar] [CrossRef]
- Zhang, Y.; Zhou, J.; Zhao, L.; Feng, Z.; Wei, F.; Bai, H.; Feng, H.; Zhu, H. A Review of the Pathogenicity Mechanism of Verticillium dahliae in Cotton. J. Cotton Res. 2022, 1, 59–71. [Google Scholar] [CrossRef]
- Inderbitzin, P.; Bostock, R.M.; Davis, R.M.; Usami, T.; Platt, H.W.; Subbarao, K.V. Phylogenetics and Taxonomy of the Fungal Vascular Wilt Pathogen Verticillium, with the Descriptions of Five New Species. PLoS ONE 2011, 6, e28341. [Google Scholar] [CrossRef]
- Liu, H.; Wang, W.; Zhang, R.; Yao, J. Investigation on the Incident Rate of Verticillium Wilt and Analysis on the Number of Microsclerotia and the Population Type of Verticillium dahliae in Soil of Northern Xinjiang. Plant Prot 2023, 49, 276–283. [Google Scholar]
- Klosterman, S.J.; Atallah, Z.K.; Vallad, G.E.; Subbarao, K.V. Diversity, Pathogenicity; and Management of Verticillium Species. Annu. Rev. Phytopathol. 2009, 47, 39–62. [Google Scholar] [CrossRef]
- Bhat, R.G.; Subbarao, K.V. Host Range Specificity in Verticillium dahliae. Phytopathology 1999, 89, 1218–1225. [Google Scholar] [CrossRef]
- Wang, Y.; Deng, C.; Tian, L.; Xiong, D.; Tian, C.; Klosterman, S.J. The Transcription Factor VdHapX Controls Iron Homeostasis and Is Crucial for Virulence in the Vascular Pathogen Verticillium dahliae. Msphere 2018, 3, e00400-18. [Google Scholar] [CrossRef]
- ElSharawy, A.; Hu, X.; Yang, J. Trade-Offs between Growth Rate, Sporulation and Pathogenicity in Verticillium dahliae. J. Agric. Sci. 2015, 7, 35–41. [Google Scholar] [CrossRef]
- Zhang, W.-W.; Jian, G.-L.; Jiang, T.-F.; Wang, S.-Z.; Qi, F.-J.; Xu, S.-C. Cotton Gene Expression Profiles in Resistant Gossypium hirsutum Cv. Zhongzhimian KV1 Responding to Verticillium dahliae Strain V991 Infection. Mol. Biol. Rep. 2012, 39, 9765–9774. [Google Scholar] [CrossRef] [PubMed]
- Isaac, I. A Further Comparative Study of Pathogenic Isolates of Verticillium: V. nubilum Pethybr. and V. Tricorpus sp. Nov. Trans. Br. Mycol. Soc. 1953, 36, 180–195. [Google Scholar] [CrossRef]
- Inderbitzin, P.; Subbarao, K.V. Verticillium Systematics and Evolution: How Confusion Impedes Verticillium Wilt Management and How to Resolve It. Phytopathology 2014, 104, 564–574. [Google Scholar] [CrossRef] [PubMed]
- Kageyama, K.; Komatsu, T.; Suga, H. Refined PCR Protocol for Detection of Plant Pathogens in Soil. J. Gen. Plant Pathol. 2003, 69, 153–160. [Google Scholar]
- Marin-Felix, Y.; Groenewald, J.Z.; Cai, L.; Chen, Q. Genera of Phytopathogenic Fungi: GOPHY 1. Stud. Mycol. 2017, 86, 99–216. [Google Scholar] [CrossRef]
- Platt, H.W.; Mahuku, G. Detection Methods for Verticillium Species in Naturally Infested and Inoculated Soils. Am. J. Potato Res. 2000, 77, 271–274. [Google Scholar] [CrossRef]
- Maruthachalam, K.; Atallah, Z.K.; Vallad, G.E.; Klosterman, S.J.; Hayes, R.J.; Davis, R.M.; Subbarao, K.V. Molecular Variation Among Isolates of Verticillium dahliae and Polymerase Chain Reaction-Based Differentiation of Races. Phytopathology 2010, 100, 1222–1230. [Google Scholar] [CrossRef] [PubMed]
- Van, T.T.; Braus-Stromeyer, S.A.; Timpner, C.; Braus, G.H. Molecular Diagnosis to Discriminate Pathogen and Apathogen Species of the Hybrid Verticillium longisporum on the Oilseed Crop Brassica napus. Appl. Microbil. Biotechnol. 2013, 97, 4467–4483. [Google Scholar] [CrossRef] [PubMed]
- Martin-Sanz, A.; Rueda, S.; Garcia-Carneros, A.B.; Gonzalez-Fernandez, S.; Miranda-Fuentes, P.; Castuera-Santacruz, S.; Molinero-Ruiz, L. Genetics, Host Range, and Molecular and Pathogenic Characterization of Verticillium dahliae from Sunflower Reveal Two Differentiated Groups in Europe. Front. Plant Sci. 2018, 9, 288. [Google Scholar] [CrossRef]
- Duressa, D.; Anchieta, A.; Chen, D.; Klimes, A.; Garcia-Pedrajas, M.D.; Dobinson, K.F.; Klosterman, S.J. RNA-Seq Analyses of Gene Expression in the Microsclerotia of Verticillium dahliae. BMC Genom. 2013, 14, 607. [Google Scholar] [CrossRef]
- Gibriel, H.; Li, J.; Zhu, L.; Seidl, M.F. Verticillium dahliae Strains That Infect the Same Host Plant Display Highly Divergent Effector Catalogs. bioRxiv 2019, 1–43. [Google Scholar]
- Chen, J.; Li, N.; Ma, X.; Gupta, V.K.; Zhang, D.; Li, T.; Dai, X. The Ectopic Overexpression of the Cotton Ve1 and Ve2-Homolog Sequences Leads to Resistance Response to Verticillium Wilt in Arabidopsis. Front. Plant Sci. 2017, 8, 844. [Google Scholar] [CrossRef] [PubMed]
- Sandoya, G.V.; Gurung, S.; Short, D.P.; Subbarao, K.V.; Michelmore, R.W.; Hayes, R.J. Genetics of Resistance in Lettuce to Races 1 and 2 of Verticillium dahliae from Different Host Species. Euphytica 2017, 213, 20. [Google Scholar] [CrossRef]
- Short, D.P.G.; Gurung, S.; Maruthachalam, K.; Atallah, Z.K.; Subbarao, K.V. Verticillium dahliae Race 2-Specific PCR Reveals a High Frequency of Race 2 Strains in Commercial Spinach Seed Lots and Delineates Race Structure. Phytopathology 2014, 104, 779–785. [Google Scholar] [CrossRef] [PubMed]
- Yang, H.; Zhang, D.; Zhang, D.; Bozorov, T.A.; Abdullaev, A.A.; Wood, A.J.; Wang, J.; Li, X.; Zhao, J. Overexpression of ALDH21 from Syntrichia caninervis Moss in Upland Cotton Enhances Fiber Quality, Boll Component Traits, and Physiological Parameters during Deficit Irrigation. Crop Sci. 2019, 59, 553–564. [Google Scholar] [CrossRef]
- Zhang, W.; Ren, Y.; Zhang, H.; Si, N.; Zhu, X.; Qi, F.; Jian, G. Genetic Variations of Prevailing Verticillium dahliae Isolates from Cotton in China. J. Plant Pathol. 2019, 101, 565–578. [Google Scholar] [CrossRef]
- Usami, T.; Ishigaki, S.; Takashina, H.; Matsubara, Y.; Amemiya, Y. Cloning of DNA Fragments Specific to the Pathotype and Race of Verticillium dahliae. J. Gen. Plant Pathol. 2007, 73, 89–95. [Google Scholar] [CrossRef]
- Rozas, J.; Ferrer-Mata, A.; Carlos Sanchez-DelBarrio, J.; Guirao-Rico, S.; Librado, P.; Ramos-Onsins, S.E.; Sanchez-Gracia, A. DnaSP 6: DNA Sequence Polymorphism Analysis of Large Data Sets. Mol. Biol. Evol. 2017, 34, 3299–3302. [Google Scholar] [CrossRef]
- Leigh, J.W.; Bryant, D. POPART: Full-Feature Software for Haplotype Network Construction. Mol. Biol. Evol. 2015, 6, 1110–1116. [Google Scholar] [CrossRef]
- Ali, M.; Ahmad, H.; Amin, B.; Atif, M.J.; Cheng, Z. Induce Defense Response of DADS in Eggplants during the Biotrophic Phase of Verticillium dahliae. BMC Plant Biol. 2022, 22, 172. [Google Scholar] [CrossRef]
- Tang, Y.; Zhang, Z.; Lei, Y.; Hu, G.; Liu, J.; Hao, M.; Chen, A.; Peng, Q.; Wu, J. Cotton WATs Modulate SA Biosynthesis and Local Lignin Deposition Participating in Plant Resistance Against Verticillium dahliae. Front. Plant Sci. 2019, 10, 526. [Google Scholar] [CrossRef] [PubMed]
- Pérez-Artés, E.; García-Pedrajas, M.D.; Bejarano-Alcázar, J.; Jiménez-Díaz, R.M. Differentiation of Cotton-Defoliating and Nondefoliating Pathotypes of Verticillium Dahliae by RAPD and Specific PCR Analyses. Eur. J. Plant Pathol. 2000, 106, 507–517. [Google Scholar] [CrossRef]
- Yan, W.; Shi, Y.-X.; Chai, A.; Xie, X.; Guo, M.; Li, B. Verticillium Wilt of Okra Caused by Verticillium dahliae Kleb. in China. Mycobiology 2018, 46, 254–259. [Google Scholar] [CrossRef] [PubMed]
- Hu, X.-P.; Gurung, S.; Short, D.P.G.; Sandoya, G.V.; Shang, W.-J.; Hayes, R.J.; Davis, R.M.; Subbarao, K.V. Nondefoliating and Defoliating Strains from Cotton Correlate with Races 1 and 2 of Verticillium dahliae. Plant Dis. 2015, 99, 1713–1720. [Google Scholar] [CrossRef] [PubMed]
- Li, N.-Y.; Ma, X.-F.; Short, D.P.G.; Li, T.-G.; Zhou, L.; Gui, Y.-J.; Kong, Z.-Q.; Zhang, D.-D.; Zhang, W.-Q.; Li, J.-J.; et al. The Island Cotton NBS-LRR Gene GbaNA1 Confers Resistance to the Non-Race 1 Verticillium dahliae Isolate Vd991. Mol. Plant Pathol. 2018, 19, 1466–1479. [Google Scholar] [CrossRef] [PubMed]
- Deng, J.X.; Li, M.J.; Paul, N.C.; Oo, M.M.; Lee, H.B.; Oh, S.-K.; Yu, S.H. Alternaria brassicifolii Sp Nov Isolated from Brassica Rapa Subsp Pekinensis in Korea. Mycobiology 2018, 46, 172–176. [Google Scholar] [CrossRef]
- Shastry, B.S. SNPs: Impact on Gene Function and Phenotype. In Single Nucleotide Polymorphisms: Methods and Protocols, Protocols, 2nd ed.; Komar, A.A., Ed.; Humana Press Inc.: Totowa, NJ, USA, 2009; Volume 578, pp. 3–22. ISBN 978-1-60327-410-4. [Google Scholar]
- Dash, M.; Somvanshi, V.S.; Godwin, J.; Budhwar, R.; Sreevathsa, R.; Rao, U. Exploring Genomic Variations in Nematode-Resistant Mutant Rice Lines. Front. Plant Sci. 2022, 13, 823372. [Google Scholar] [CrossRef]

Disclaimer/Publisher’s Note: The statements, opinions and data contained in all publications are solely those of the individual author(s) and contributor(s) and not of MDPI and/or the editor(s). MDPI and/or the editor(s) disclaim responsibility for any injury to people or property resulting from any ideas, methods, instructions or products referred to in the content. |
© 2024 by the authors. Licensee MDPI, Basel, Switzerland. This article is an open access article distributed under the terms and conditions of the Creative Commons Attribution (CC BY) license (https://creativecommons.org/licenses/by/4.0/).
Share and Cite
Zhang, J.; Jiamahate, A.; Feng, H.; Bozorov, T.A.; Zhang, D.; Guo, J.; Yang, H.; Zhang, D. Distribution and Pathogenicity Differentiation of Physiological Races of Verticillium dahliae from Cotton Stems in Western China. Pathogens 2024, 13, 525. https://doi.org/10.3390/pathogens13070525
Zhang J, Jiamahate A, Feng H, Bozorov TA, Zhang D, Guo J, Yang H, Zhang D. Distribution and Pathogenicity Differentiation of Physiological Races of Verticillium dahliae from Cotton Stems in Western China. Pathogens. 2024; 13(7):525. https://doi.org/10.3390/pathogens13070525
Chicago/Turabian StyleZhang, Jianwei, Aerguli Jiamahate, Hui Feng, Tohir A. Bozorov, Dawei Zhang, Jianwei Guo, Honglan Yang, and Daoyuan Zhang. 2024. "Distribution and Pathogenicity Differentiation of Physiological Races of Verticillium dahliae from Cotton Stems in Western China" Pathogens 13, no. 7: 525. https://doi.org/10.3390/pathogens13070525
APA StyleZhang, J., Jiamahate, A., Feng, H., Bozorov, T. A., Zhang, D., Guo, J., Yang, H., & Zhang, D. (2024). Distribution and Pathogenicity Differentiation of Physiological Races of Verticillium dahliae from Cotton Stems in Western China. Pathogens, 13(7), 525. https://doi.org/10.3390/pathogens13070525

